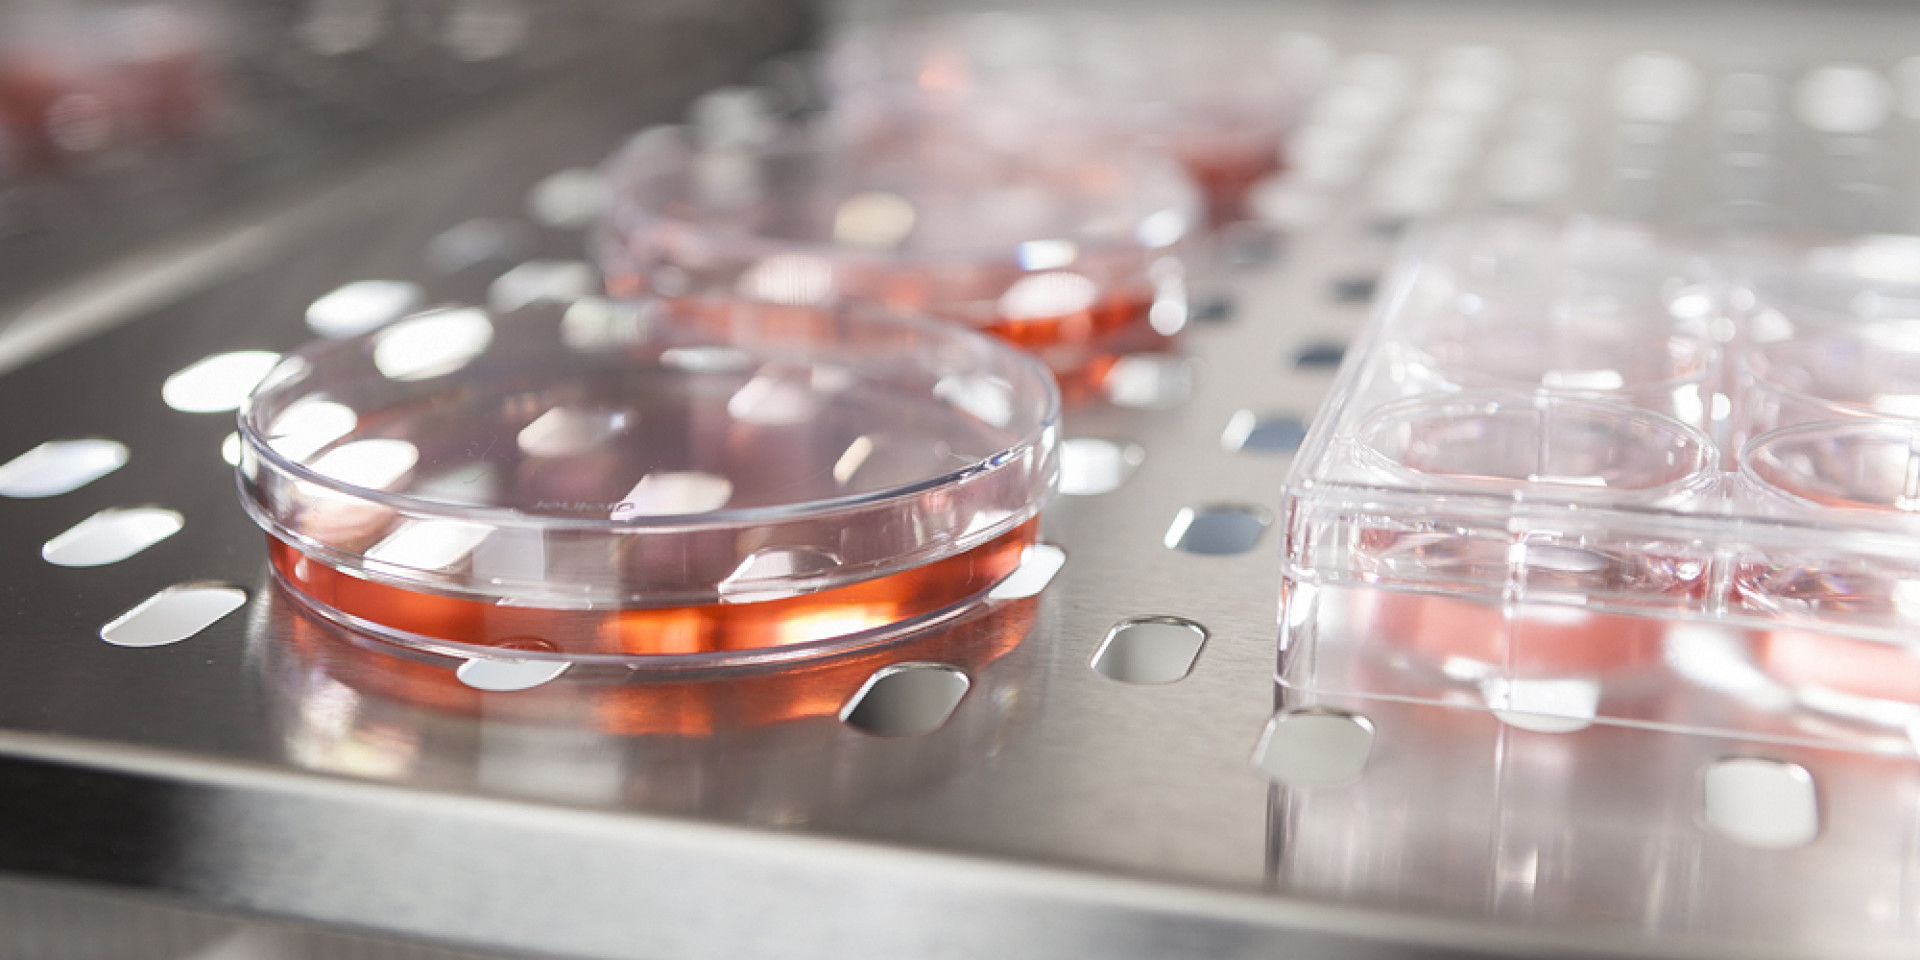
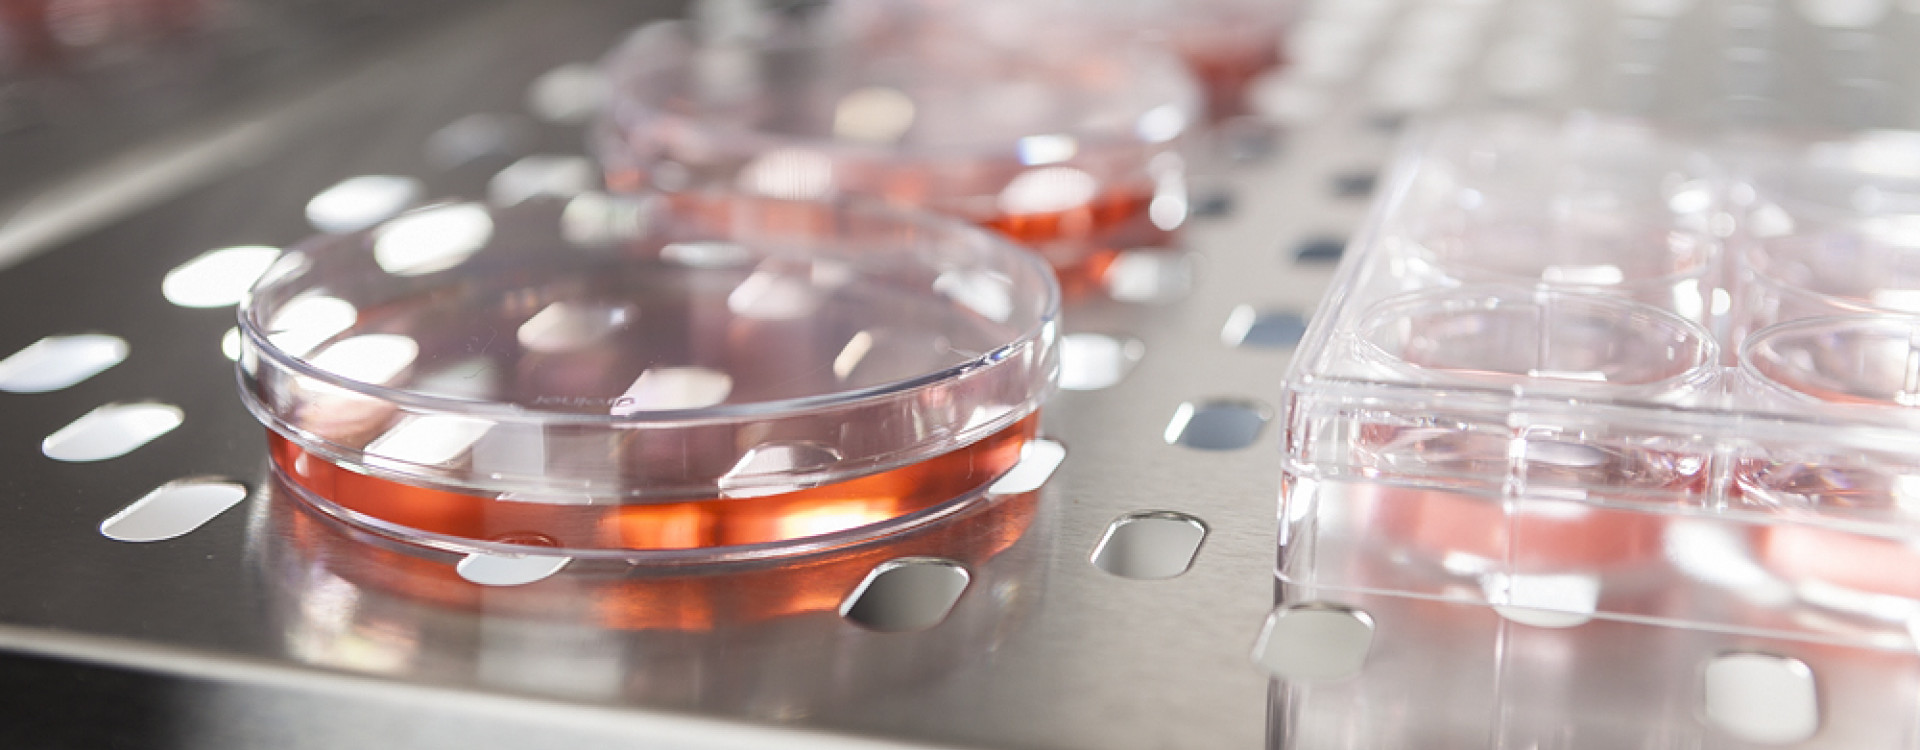
Institut für Angewandte Biotechnologie

With the establishment of the Institute for Applied Biotechnology (IAB), the prerequisites for anchoring biotechnological research and development at Biberach University were created. The IAB is located at the university site in Aspach in the PBT building and complements the degree programs "Pharmaceutical Biotechnology" and "Industrial Biotechnology" with a correspondingly oriented research program.
The core competence of the institute is the manufacturing process for biopharmaceuticals as well as for industrial (white) biotechnology products. In the various laboratories of the Institute of Applied Biotechnology, the complete biotechnological manufacturing process is mapped - from the establishment of cell lines and microorganisms to fermentation, protein purification and protein analysis. The state-of-the-art equipment of the laboratories of the degree programs and the IAB enables the processing of current and trendsetting projects in these areas.


The Institute for Applied Biotechnology (IAB) at Biberach University of Applied Sciences focuses on the biotechnological manufacturing process. The cooperation of the individual laboratories enables the research and development of individual sub-aspects, but also the further development and implementation of the entire process from the cloning of a gene to the purification and analysis of the product.
IAB's research projects are both publicly funded projects and contract research projects. They are realized in cooperation with industry as well as national and international universities. Furthermore, IAB offers research projects for seminar papers, bachelor`s & master`s theses.
In our institute, numerous research groups are working on various projects. Here you can get an overview:
IAB's laboratory equipment enables external and internal research, development and contract work. The research groups are thematically and technically oriented to the common thread of the manufacturing process for biopharmaceuticals and work across disciplines.
IAB has expertise in numerous disciplines, including molecular biology, genetic engineering, microbiology, fermentation and cell culture technology.


Our Director of the institute is happy to advise and assist you!
